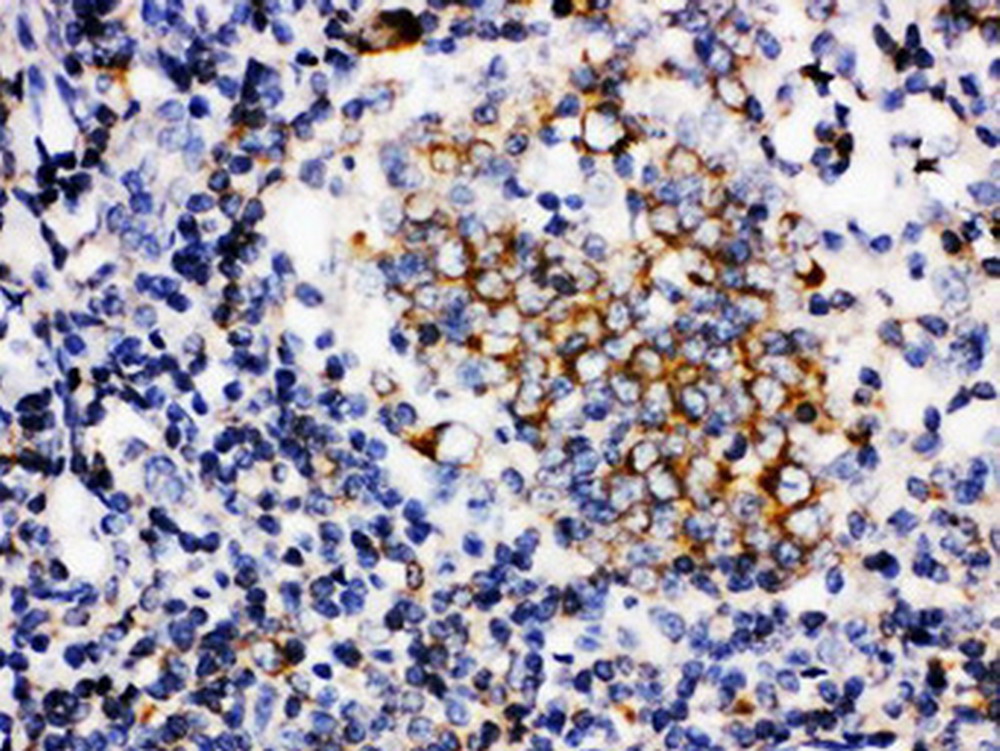
baff(ba4037)扁桃体标本,石蜡切片,sabc法,dab显色.

扁桃体切片

扁桃体切片
图片尺寸600x372
双扁桃体低温等离子切除术
图片尺寸1079x1439
熟人的扁桃体请大家帮忙看看
图片尺寸800x600
慢性扁桃体炎
图片尺寸272x240
益阳医专附属医院五官科开展等离子切除扁桃体腺样体微创手术
图片尺寸1080x1440
邢台市人民医院耳鼻喉科等离子射频消融扁桃体及腺样体治疗小儿鼾症
图片尺寸1196x1596
扁桃体肿物病例讨论
图片尺寸1080x608
扁桃体,这是什么?
图片尺寸965x777
扁桃体肿物病例讨论
图片尺寸1080x608
6.扁桃体-颚(he 染色1070154)
图片尺寸1701x1606
baff(ba4037)扁桃体标本,石蜡切片,sabc法,dab显色.
图片尺寸1000x751
扁桃体肿物病例讨论
图片尺寸1080x608
右侧扁桃体新生物.肿瘤?良性病变?
图片尺寸744x554
扁桃体
图片尺寸336x318
右侧扁桃体新生物.肿瘤?良性病变?
图片尺寸744x554
扁桃体切除能报销学生险吗 学平险可以报销孩子扁桃体手术吗
图片尺寸320x255
了解儿童扁桃体炎
图片尺寸642x964
扁桃体专题
图片尺寸400x284
扁桃体肿物病例讨论
图片尺寸1080x608
人类扁桃体中的c4d,克隆12d11染色冷冻切片
图片尺寸600x448